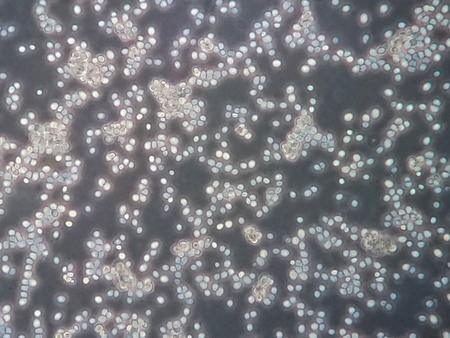
Yeast cells under microscope viewの写真素材

写真素材 - Yeast cells under microscope view
キーワード
- albicans
- ascomycota
- background
- bacteria
- beer
- beverages
- biofuel
- biology
- biotechnology
- body
- brewing
- budding
- candida
- candidiasis
- cell
- cerevisiae
- disease
- form
- fungal
- fungi
- fungus
- health
- hospital
- hyphae
- hyphal
- illness
- infection
- isolated
- lab
- laboratory
- life
- medical
- medicine
- microbiology
- microorganism
- microscopic
- mushroom
- nature
- pathogen
- render
- saccharomyces
- science
- septa
- small
- treatment
- unicellular
- white
- yeast
類似作品
Bacterial colon...
microscope lens...
Lily cell meios...
Oil bubbles ins...
Pancreas cancer...
Bacteria methic...
ink drops
Spheroids of gl...
Abstract creati...
Microscopic vie...
Cell division u...
budding yeast c...
stool specimen ...
Red caviar
Blood pigcon un...
Moderate bacter...
Slice of mushro...
Cosmetic hydrat...
Amphibian blood...
a molecule of g...
View of the Uri...
Smear of Gram's...
Microscope with...
Pancreas cancer...
Slide sputum AF...
Oil bubbles ins...
Smear of Positi...
Club moss flowe...
Backgrounds of ...
Abstract patter...
view through th...
Onion root tip ...
Budding yeast w...
Artistic backgr...
Harmonic backgr...
Microscopic vie...
Smear of Acid-F...
Dangerous head ...
These Gram-nega...
Smear of Acid-F...
Colorful abstra...
modern design b...
Color image in ...
Blood picture t...
Close-up of pin...
Lily anther cel...
Mitosis cell of...
Morphology of b...
abstract small ...